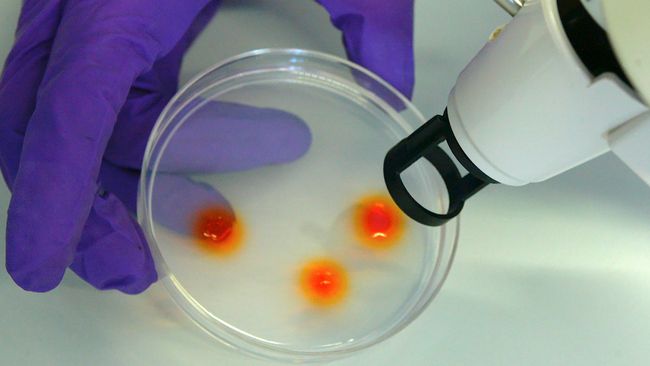

Tvistens
Missionshus
Tvistens Frikyrkoförsamling
Debatt
Här publicerar vi inlägg och synpunkter från oss liksom från besökarna på vår hemsida
Vill du göra ett inlägg? Använd kontaktformuläret på sidan "Kontakt"!
Hjälp oss att be för vårt barnbarn: att det blir helat från diabetessjukdom och att familjen blir välsignad.
Tack
med välsignelse ,Keijo södertälje
Apropå terrordåden i Bryssel
”Kombinera säkerhet med integritet som i Israel”
En lärdom kommer från ett land som lever med terrorn dagligen: Israel.
Säkerhetsnivån på Israels största flygplats Ben Gurion är hög, fast givet den höga risken som landet är utsatt för känns den inte tryckande påträngande.
Inget flygplan som lyft från Ben Gurion har kapats och även den givna måltavlan för terror, flygbolaget El Al, har inte sett ett attentat på årtionden.
Nu blommar det – dödsdalen lever upp
Besökare från hela världen förundras över den mycket ovanliga händelsen. Death Valley, ökenområdet som är Nordamerikas varmaste och torraste plats, har slagit ut i full blom.
Nytt israeliskt cancervaccin utlöser reaktion i 90% av cancertyper
Allt fler får nej till personlig assistans
Nya siffror Mer än varannan sökande får nej till personlig assistans.
Farlig resistensgen redan spridd
”ett mardrömsscenario”
Den gen som upptäcktes nyligen i Kina och som är motståndskraftig mot den ”sista” sortens antibiotika är redan spridd över världen, skriver New Scientist.
Kina-fabrik hoppas kunna klona människor
3 timmar sedan
Arbete med kloning i laboratorium
Världens största kloningsfabrik öppnar inom kort i Kina. Till en början ska bara djur klonas, men förhoppningen är att även kunna klona människor - om det blir socialt accepterat.
(SVT)
Varannan trädart i Amazonas har blivit så ovanlig att den riskerar att försvinna. Forskare larmar nu om att situationen är än mer kritisk än vad som tidigare varit känt.
Amazonas regnskogar har krymt sedan 1950-talet på grund av avverkning, men först nu börjar forskare kunna se hur detta påverkat enskilda trädarter.
FLYKTING-
KATASTROFEN 2015
Peter Wolodarski: Flyktingkrisen är en skam för Europas demokratier
Publicerad i Dagens Nyheter 2015-10-10 23:27
Tjernobyl fortfarande en dödlig zon
Vetenskapsjournalisten Derek Muller har besökt Tjernobyl, 30 år efter kärnkraftsexplosionen.
Än i dag, 30 år efter det som kallats världens största kärnkraftsexplosion är strålningen på vissa ställen livsfarlig i Tjernobyl. Nu byggs en ny jättesarkofag som ska täcka det havererade kärnkraftverket. Men inte ens den kommer räcka på lång sikt